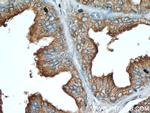
ACPP Antibody in Immunohistochemistry (Paraffin) (IHC (P))

Search
Proteintech
ACPP Monoclonal Antibody (1G2C9)
{{$productOrderCtrl.translations['antibody.pdp.commerceCard.promotion.promotions']}}
{{$productOrderCtrl.translations['antibody.pdp.commerceCard.promotion.viewpromo']}}
{{$productOrderCtrl.translations['antibody.pdp.commerceCard.promotion.promocode']}}: {{promo.promoCode}} {{promo.promoTitle}} {{promo.promoDescription}}. {{$productOrderCtrl.translations['antibody.pdp.commerceCard.promotion.learnmore']}}
产品信息
60176-1-IG
种属反应
宿主/亚型
分类
类型
克隆号
抗原
偶联物
形式
浓度
规格
纯化类型
保存液
内含物
保存条件
运输条件
产品详细信息
Immunogen sequence: DRSVLAKEL KFVTLVFRHG DRSPIDTFPT DPIKESSWPQ GFGQLTQLGM EQHYELGEYI RKRYRKFLNE SYKHEQVYIR STDVDRTLMS AMTNLAALFP PEGVSIWNPI LLWQPIPVHT VPLSEDQLLY LPFRNCPRFQ ELESETLKSE EFQKRLHPYK DFIATLGKLS GLHGQDLFGI WSKVYDPLYC ESVHNFTLPS WATEDTMTKL RELSELSLLS LYGIHKQKEK SRLQGGVLVN EILNHMKRAT QIPSYKKLIM YSAHDTTVSG LQMALDVYNG LLPPYASCHL TELYFEKGEY FVEMYYRNET QHEPYPLMLP GCSPSCPLER FAELAGPVIP QDWSTECM (27-373 aa encoded by BC007460 )
靶标信息
ACPP is an enzyme which catalyzes the conversion of orthophosphoric monoester to alcohol and orthophosphate. It is synthesized under androgen regulation and is secreted by the epithelial cells of the prostate gland.
仅用于科研。不用于诊断过程。未经明确授权不得转售。
生物信息学
蛋白别名: 5'-NT; 5'-nucleotidase; Acid phosphatase 3; acid phosphatase, prostate; EC 3.1.3.2; Ecto-5'-nucleotidase; Fluoride-resistant acid phosphatase; FRAP; PAP; PPAP; prostate acid phosphatase; Prostatic acid phosphatase; prostatic acid phosphatase (rPAP); prostatic acid phosphotase; Protein tyrosine phosphatase ACP3; Thiamine monophosphatase; TMPase; unnamed protein product
基因别名: 5'-NT; ACP-3; ACP3; ACPP; Acpp11; FRAP; pap; Ppal; RNACPP11; TM-PAP
UniProt ID: (Human) P15309, (Rat) P20646
Entrez Gene ID: (Human) 55, (Rat) 56780